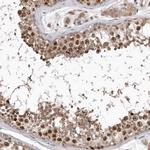
CDCA8 Antibody in Immunohistochemistry (IHC)

Search
Invitrogen
CDCA8 Polyclonal Antibody
{{$productOrderCtrl.translations['antibody.pdp.commerceCard.promotion.promotions']}}
{{$productOrderCtrl.translations['antibody.pdp.commerceCard.promotion.viewpromo']}}
{{$productOrderCtrl.translations['antibody.pdp.commerceCard.promotion.promocode']}}: {{promo.promoCode}} {{promo.promoTitle}} {{promo.promoDescription}}. {{$productOrderCtrl.translations['antibody.pdp.commerceCard.promotion.learnmore']}}
产品信息
PA5-55771
种属反应
已发表种属
宿主/亚型
分类
类型
抗原
偶联物
形式
浓度
规格
纯化类型
保存液
内含物
保存条件
运输条件
RRID
产品详细信息
Immunogen sequence: PLKSAKTRKV IQVDEMIVEE EEEEENERKN LQTARVKRCP PSKKRTQSIQ GKGKGKRSSR ANTVTPAVGR LEVSMVKPTP GLTPRFDSR
Highest antigen sequence identity to the following orthologs: Mouse - 64%, Rat - 66%.
靶标信息
CDCA8 is a component of a chromosomal passenger complex (CPC) required for stability of the bipolar mitotic spindle. The chromosomal passenger complex, which includes Survivin, CDCA8, INCENP and Aurora-B, is known to play crucial roles during mitosis and cell division. It was found that CDCA8 interacting with Aurora-B, INCENP and Survivin, increases during G2/M phase and then reduces after exit from M phase. CDCA8 is cell cycle regulated, down-regulated in response to p53/Rb-signaling, and up-regulated in many types of cancerous tissues. In Drosophila cells, inactivation of CDCA8 results in polyploidy, delayed mitosis and abnormal tissue development, indicating its critical role for cell proliferation. Recent studies show that CDCA8 is essential for cell proliferation during early embryonic development, and its early embryonic lethality cannot be rescued by the loss of p53. Its aberrant expression is linked to a poor prognosis for gastric cancer.
仅用于科研。不用于诊断过程。未经明确授权不得转售。
生物信息学
蛋白别名: Borealin; Cell division cycle-associated protein 8; Dasra B; Dasra-B; hDasra-B; HPESCRG3; Pluripotent embryonic stem cell-related gene 3 protein; unnamed protein product
基因别名: BOR; BOREALIN; CDCA8; DasraB; MESRGP; PESCRG3
UniProt ID: (Human) Q53HL2
Entrez Gene ID: (Human) 55143